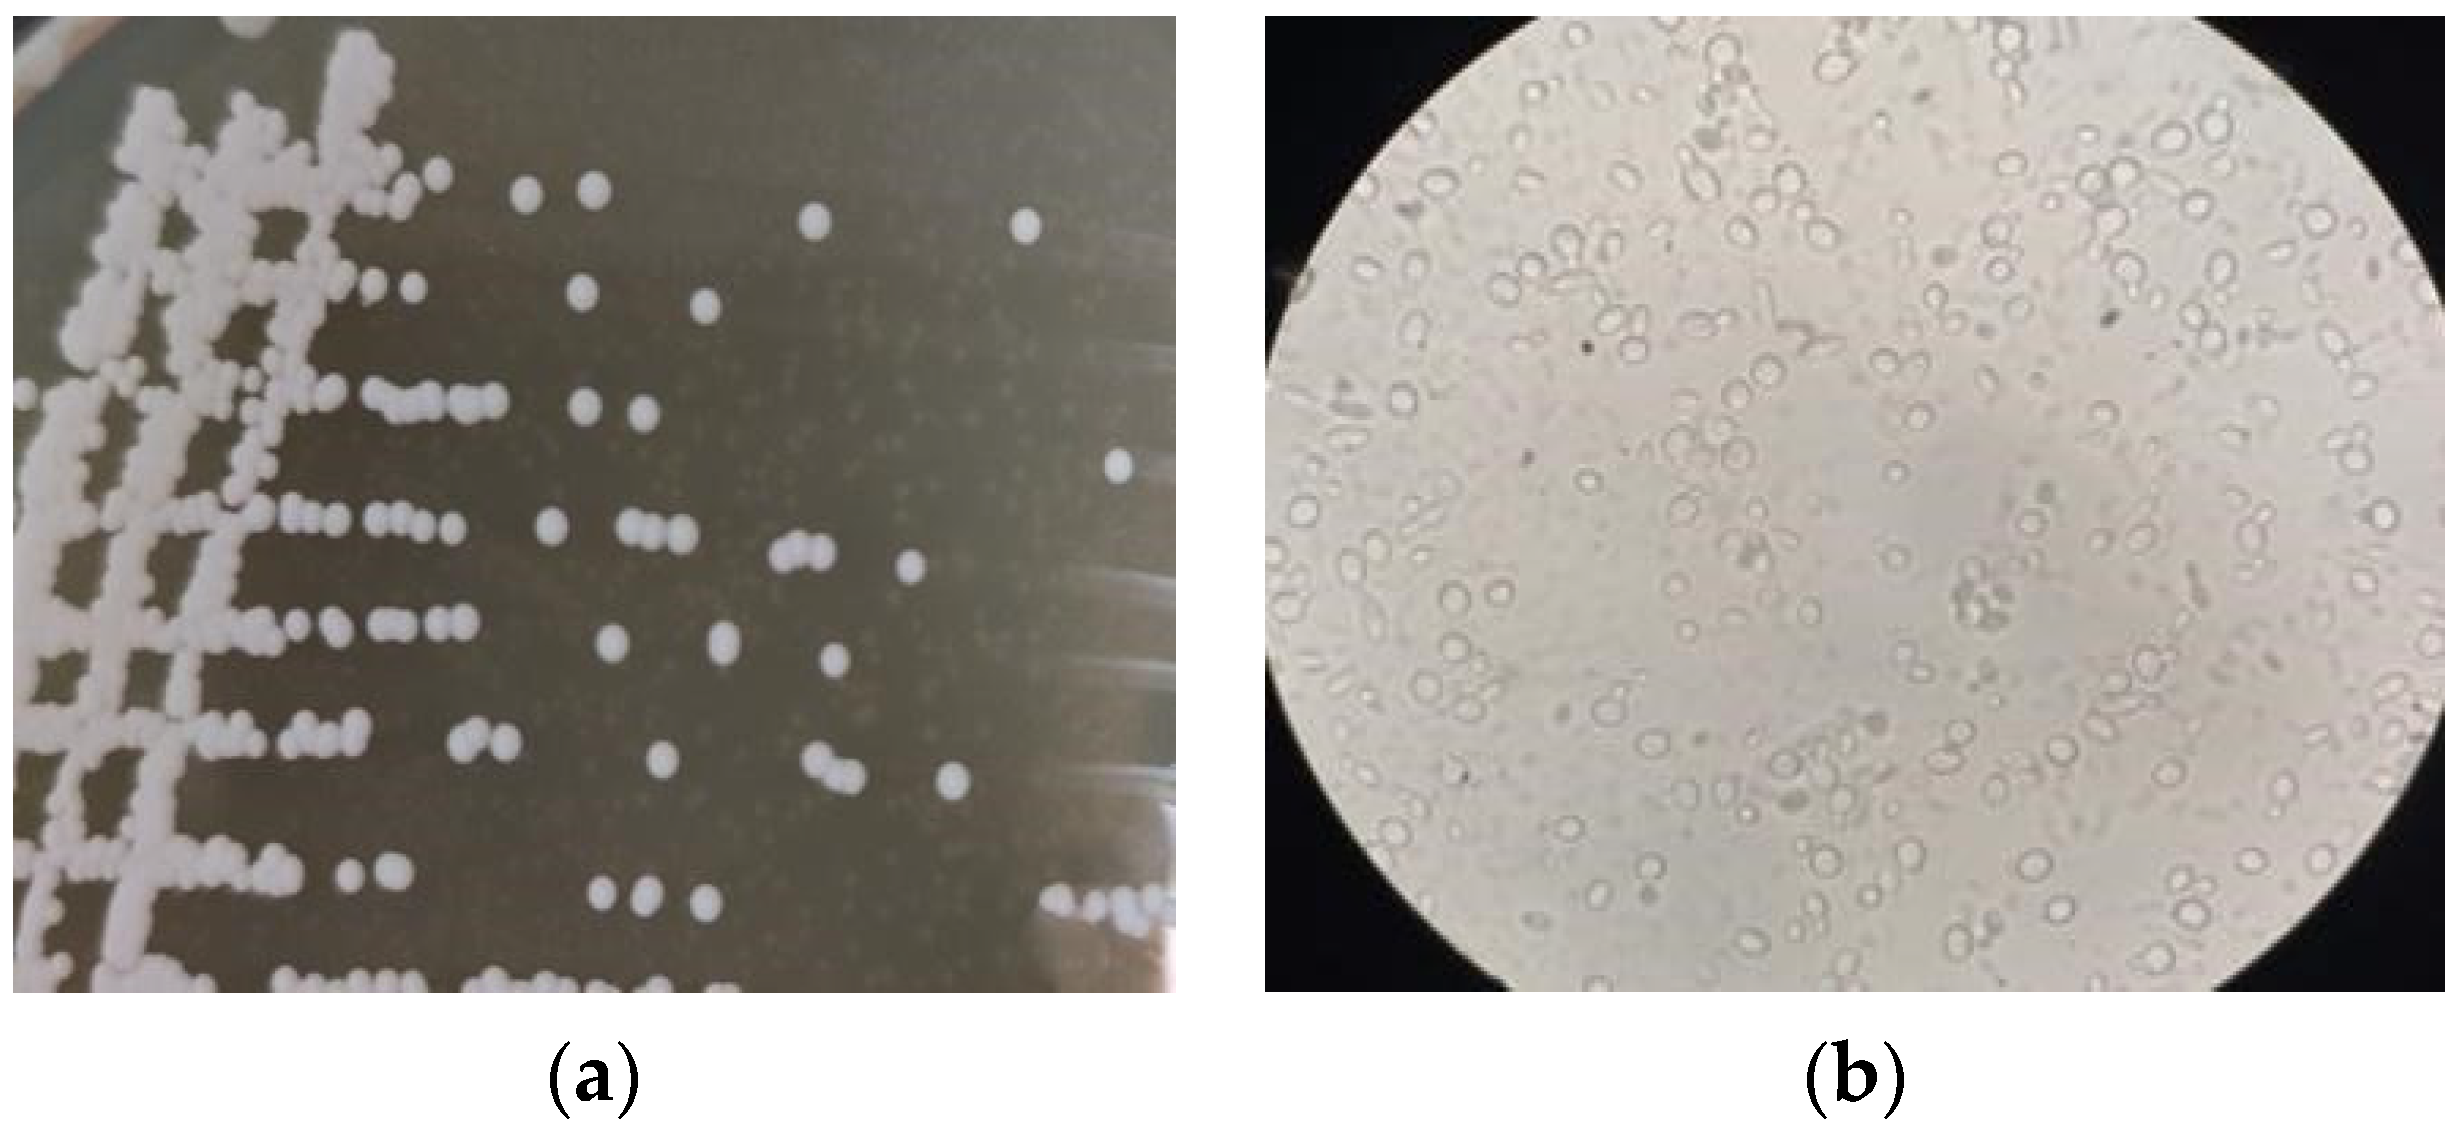

Isolation of Aroma-Producing Wickerhamomyces anomalus Yeast and Analysis of Its Typical Flavoring Metabolites
Abstract
1. Introduction
2. Materials and Methods
2.1. Materials
2.2. Isolation and Screening of Aromatic Yeast
2.3. Performance Determination of Aroma-Producing Yeast Strains
2.4. Identification of Aroma-Producing Yeast
2.4.1. Morphological Observation
2.4.2. Molecular Biological Identification
2.5. Fermentation of SCP
2.6. Liquid Aroma Production Experiment of Aroma-Producing Yeast
2.7. Sensory Evaluation
2.8. Data Analysis
3. Results and Discussion
3.1. Screening of Aroma-Producing Yeast
3.2. Determination of Salt and Acid Resistance
3.3. White Colony or Buffy Coat Formation Assay
3.4. Determination of Cellulose and Pectinase
3.5. Y3 Yeast Identification Results
3.5.1. Morphological Characteristics of the Strain
3.5.2. Molecular Biological Identification of Y3 Strain
3.6. Liquid Aroma Production Experiment of Aroma-Producing Yeast
3.7. Sensory Evaluation
4. Conclusions
Author Contributions
Funding
Data Availability Statement
Conflicts of Interest
References
- Luo, Y.; Liu, Y.; Ren, T.; Wang, B.; Peng, Y.; Zeng, S.; Su, Y. Sichuan paocai fermented by mixed-starter culture of lactic acid bacteria. Food Sci. Nutr. 2020, 8, 5402–5409. [Google Scholar] [CrossRef] [PubMed]
- Park, S.E.; Seo, S.H.; Kim, E.J.; Byun, S.; Na, C.S.; Son, H.S. Changes of microbial community and metabolite in kimchi inoculated with different microbial community starters. Food Chem. 2019, 274, 558–565. [Google Scholar] [CrossRef] [PubMed]
- Xia, Y.; Liu, X.; Wang, G.; Zhang, H.; Xiong, Z.; Sun, Y.; Ai, L. Characterization and selection of Lactobacillus brevis starter for nitrite degradation of Chinese pickle. Food Control 2017, 78, 126–131. [Google Scholar] [CrossRef]
- Gamero, A.; Quintilla, R.; Groenewald, M.; Alkema, W.; Boekhout, T.; Hazelwood, L. High-throughput screening of a large collection of non-conventional yeasts reveals their potential for aroma formation in food fermentation. Food Microbiol. 2016, 60, 147–159. [Google Scholar] [CrossRef] [PubMed]
- Rojas, V.; Gil, J.V.; Piñaga, F.; Manzanares, P. Studies on acetate ester production by non-Saccharomyces wine yeasts. Int. J. Food Microbiol. 2001, 70, 283–289. [Google Scholar] [CrossRef]
- Li, Y.C.; Rao, J.W.; Meng, F.B.; Wang, Z.W.; Liu, D.Y.; Yu, H. Combination of mutagenesis and adaptive evolution to engineer salt-tolerant and aroma-producing yeast for soy sauce fermentation. J. Sci. Food Agric. 2021, 101, 4288–4297. [Google Scholar] [CrossRef]
- Jiang, X.; Peng, D.; Zhang, W.; Duan, M.; Ruan, Z.; Huang, S.; Zhou, S.; Fang, Q. Effect of aroma-producing yeasts in high-salt liquid-state fermentation soy sauce and the biosynthesis pathways of the dominant esters. Food Chem. 2021, 344, 128681. [Google Scholar] [CrossRef]
- Solieri, L.; Giudici, P. Yeasts associated to Traditional Balsamic Vinegar: Ecological and technological features. Int. J. Food Microbiol. 2008, 125, 36–45. [Google Scholar] [CrossRef]
- Yan, S.; Xiangsong, C.; Xiang, X. Improvement of the aroma of lily rice wine by using aroma-producing yeast strain Wickerhamomyces anomalus HN006. AMB Express 2019, 9, 89. [Google Scholar] [CrossRef]
- Seo, H.; Bae, J.H.; Kim, G.; Kim, S.A.; Ryu, B.H.; Han, N.S. Suitability Analysis of 17 Probiotic Type Strains of Lactic Acid Bacteria as Starter for Kimchi Fermentation. Foods 2021, 10, 1435. [Google Scholar] [CrossRef]
- Park, W.J.; Kong, S.J.; Park, J.H. Kimchi bacteriophages of lactic acid bacteria: Population, characteristics, and their role in watery kimchi. Food Sci. Biotechnol. 2021, 30, 949–957. [Google Scholar] [CrossRef]
- Ao, X.; Yan, J.; Chen, C.; Zhao, J.; Liu, S.; Zhao, K.; Chen, S.; He, L. Isolation and identification of the spoilage microorganisms in Sichuan homemade Paocai and their impact on quality and safety. Food Sci. Nutr. 2019, 7, 2939–2947. [Google Scholar] [CrossRef] [PubMed]
- Bhadrecha, P.; Bala, M.; Khasa, Y.P.; Arshi, A.; Singh, J.; Kumar, M. Hippophae rhamnoides L. rhizobacteria exhibit diversified cellulase and pectinase activities. Physiol. Mol. Biol. Plants 2020, 26, 1075–1085. [Google Scholar] [CrossRef] [PubMed]
- Wanmolee, W.; Sornlake, W.; Rattanaphan, N.; Suwannarangsee, S.; Laosiripojana, N.; Champreda, V. Biochemical characterization and synergism of cellulolytic enzyme system from Chaetomium globosum on rice straw saccharification. BMC Biotechnol. 2016, 16, 82. [Google Scholar] [CrossRef]
- Xiu, L.; Kunliang, G.; Hongxun, Z. Determination of microbial diversity in Daqu, a fermentation starter culture of Maotai liquor, using nested PCR-denaturing gradient gel electrophoresis. World J. Microbiol. Biotechnol. 2012, 28, 2375–2381. [Google Scholar] [CrossRef] [PubMed]
- Zhang, X.; Li, Y.; Zhao, Y.; Guan, H.; Jin, C.; Gong, H.; Sun, X.; Wang, P.; Li, H.; Liu, W. Effect of Levilactobacillus brevis as a starter on the flavor quality of radish paocai. Food Res. Int. 2023, 168, 112780. [Google Scholar] [CrossRef] [PubMed]
- Fu, Z.; Sun, B.; Li, X.; Fan, G.; Teng, C.; Alaa, A.; Jia, Y. Isolation and characterization of a high ethyl acetate-producing yeast from Laobaigan Daqu and its fermentation conditions for producing high-quality Baijiu. Biotechnol. Biotechnol. Equip. 2018, 32, 1218–1227. [Google Scholar] [CrossRef]
- Zhang, Y.; Zhang, Y.; Zhu, Y.; Mao, S.; Li, Y. Proteomic analyses to reveal the protective role of glutathione in resistance of Lactococcus lactis to osmotic stress. Appl. Environ. Microbiol. 2010, 76, 3177–3186. [Google Scholar] [CrossRef]
- Hossain, M.S.; Dietz, K.J. Tuning of Redox Regulatory Mechanisms, Reactive Oxygen Species and Redox Homeostasis under Salinity Stress. Front. Plant Sci. 2016, 7, 548. [Google Scholar] [CrossRef]
- Xiao, Y.; Xiong, T.; Peng, Z.; Liu, C.; Huang, T.; Yu, H.; Xie, M. Correlation between microbiota and flavours in fermentation of Chinese Sichuan Paocai. Food Res. Int. 2018, 114, 123–132. [Google Scholar] [CrossRef]
- Suzuki, A.; Muraoka, N.; Nakamura, M.; Yanagisawa, Y.; Amachi, S. Identification of undesirable white-colony-forming yeasts appeared on the surface of Japanese kimchi. Biosci. Biotechnol. Biochem. 2018, 82, 334–342. [Google Scholar] [CrossRef] [PubMed]
- Kurtzman, C.P. Phylogeny of the ascomycetous yeasts and the renaming of Pichia anomala to Wickerhamomyces anomalus. Antonie Van Leeuwenhoek 2011, 99, 13–23. [Google Scholar] [CrossRef] [PubMed]
- Tian, S.; Liang, X.; Chen, J.; Zeng, W.; Zhou, J.; Du, G. Enhancement of 2-phenylethanol production by a wild-type Wickerhamomyces anomalus strain isolated from rice wine. Bioresour. Technol. 2020, 318, 124257. [Google Scholar] [CrossRef] [PubMed]
- Zhang, Q.; Huo, N.; Wang, Y.; Zhang, Y.; Wang, R.; Hou, H. Aroma-enhancing role of Pichia manshurica isolated from Daqu in the brewing of Shanxi Aged Vinegar. Int. J. Food Prop. 2017, 20, 2169–2179. [Google Scholar] [CrossRef]
- Fan, W.; Qian, M.C. Characterization of aroma compounds of chinese “Wuliangye” and “Jiannanchun” liquors by aroma extract dilution analysis. J. Agric. Food Chem. 2006, 54, 2695–2704. [Google Scholar] [CrossRef]
- Cao, Y.; Wu, Z.; Weng, P. Comparison of bayberry fermented wine aroma from different cultivars by GC-MS combined with electronic nose analysis. Food Sci. Nutr. 2020, 8, 830–840. [Google Scholar] [CrossRef]
- Aissani, N.; Tedeschi, P.; Maietti, A.; Brandolini, V.; Garau, V.L.; Caboni, P. Nematicidal activity of allylisothiocyanate from horseradish (Armoracia rusticana) roots against Meloidogyne incognita. J. Agric. Food Chem. 2013, 61, 4723–4727. [Google Scholar] [CrossRef]

| Number | Y3 | Y4 | Y5 | Y6 | Y7 |
|---|---|---|---|---|---|
| Flavor characteristic | Ester, fruit and wine aromas | Ester, floral, wine aroma | Ester, fruit and wine aromas | Ester aroma, wine aroma | Ester aroma, wine aroma |
| Fragrance intensity | +++++ | ++++ | +++++ | +++ | ++++ |
| Strains | Y3 | Y4 | Y5 | Y6 | Y7 |
|---|---|---|---|---|---|
| White-colony formation | − | − | − | + | − |
| Strains | Y3 | Y4 | Y5 | Y6 | Y7 |
|---|---|---|---|---|---|
| Cellulose | − | − | − | − | − |
| Pectinase | − | − | − | − | − |
| Number | Aroma Compounds | Compound RT (min) | Relative Content (%) | |||
|---|---|---|---|---|---|---|
| Control | 1:1 | 2:1 | 3:1 | |||
| Esters | ||||||
| ES1 | Ethyl acetate | 6.8 | ND | 0.48 ± 0.02 | ND | ND |
| ES2 | Ethyl hydride oxamate | 10.655 | ND | 0.17 ± 0.03 a | ND | 0.151 ± 0.007 a |
| ES3 | Dimethyl oxalate | 12.032 | ND | 0.15 ± 0.05 | ND | ND |
| ES4 | Allyl isothiocyanate | 16.498 | 33.6 ± 0.4 b | 2.16 ± 0.14 d | 63.295 ± 3.1 a | 6.531 ± 0.48 c |
| ES5 | Isobutyl isothiocyanate | 17.029 | ND | 0.89 ± 0.06 b | 1.178 ± 0.15 b | 2.987 ± 0.32 a |
| ES6 | (+/−)-3-Hydroxy-r-butyrolactone | 19.144 | ND | 0.22 ± 0.01 | ND | ND |
| ES7 | 3-Butenyl isothiocyanate | 22.932 | ND | 9.79 ± 0.07 b | 5.096 ± 0.41 c | 32.932 ± 0.85 a |
| ES8 | 4-Hydroxybutyrolactone | 27.566 | ND | 0.127 ± 0.01 | ND | ND |
| ES9 | β-Phenylethyl isothiocyanate | 37.33 | 7.57 ± 0.72 b | 27.94 ± 2.93 a | 6.226 ± 0.304 b | 29.609 ± 1.951 a |
| ES10 | Sec-butyl chloroformate | 37.33 | ND | ND | 0.844 ± 0.09 | ND |
| ∑ | 41.17 | 41.927 | 76.639 | 72.21 | ||
| Aldehydes | ||||||
| AD1 | Aldol | 10.655 | 0.82 ± 0.055 a | 0.12 ± 0.017 b | ND | ND |
| AD2 | Hexanal | 11.392 | 1.34 ± 0.27 a | ND | 0.23 ± 0.04 b | ND |
| AD3 | Glutaraldehyde | 18.165 | 0.7 ± 0.006 | ND | ND | ND |
| AD4 | Nonanal | 24.02 | ND | ND | 0.12 ± 0.011 | ND |
| AD5 | Benzaldehyde | 24.02 | ND | ND | 0.421 ± 0.024 | ND |
| AD6 | Heptanal | 26.237 | ND | ND | ND | 0.667 ± 0.03 |
| AD7 | Pentanal | 27.566 | ND | 1.17 ± 0.12 | ND | ND |
| ∑ | 2.86 | 1.29 | 0.771 | 0.667 | ||
| Alcohols | ||||||
| AL1 | (S)-Glycerol | 8.389 | 0.17 ± 0.034 b | 0.65 ± 0.11 a | ND | ND |
| AL2 | 2-Amino-1-propanol | 12.032 | ND | ND | ND | 0.738 ± 0.05 |
| AL3 | Isobutyl alcohol | 12.032 | ND | 0.093 ± 0.01 | ND | ND |
| AL4 | n-Butyl alcohol | 13.579 | 0.34 ± 0.015 | ND | ND | ND |
| AL5 | Isoamyl alcohol | 16.498 | ND | ND | 1.159 ± 0.03 | ND |
| AL6 | 1-Pentanol | 17.029 | 1.33 ± 0.06 a | 0.45 ± 0.06 b | ND | ND |
| AL7 | Glycidol | 19.144 | 0.17 ± 0.01 | ND | ND | ND |
| AL8 | n-Hexanol | 20.02 | ND | 0.62 ± 0.025 a | ND | 0.605 ± 0.029 a |
| AL9 | Cyclopropyl carbinol | 24.02 | ND | 0.84 ± 0.07 | ND | ND |
| AL10 | Isooctanol | 24.02 | ND | ND | 2.276 ± 0.23 | ND |
| AL11 | Cyclobutanol | 24.02 | ND | 0.71 ± 0.03 | ND | ND |
| AL12 | 2-Ethyl hexanol | 24.02 | 2.42 ± 0.31 | ND | ND | ND |
| AL13 | 1-Octanol | 25.458 | ND | ND | 0.269 ± 0.002 b | 0.963 ± 0.012 a |
| AL14 | Sec-hexanol | 26.237 | ND | ND | 0.423 ± 0.02 | ND |
| AL15 | 1-Nonanol | 27.566 | ND | ND | 0.396 ± 0.013 | ND |
| AL16 | Alpha-terpineol | 28.829 | ND | ND | 0.162 ± 0.014 | ND |
| AL17 | Cyclobutanol | 29.306 | 0.37 ± 0.02 b | ND | ND | 0.778 ± 0.05 a |
| AL18 | Phenylethyl alcohol | 33.101 | ND | 6.68 ± 0.35 a | 1.1 ± 0.062 c | 2.329 ± 0.17 b |
| AL19 | 1,2,3-Butanetriol | 33.101 | ND | 4.64 ± 0.68 | ND | ND |
| AL20 | 2-Ethoxyethanol | 36.025 | ND | 12.48 ± 0.51 a | 2.008 ± 0.11 b | ND |
| ∑ | 4.8 | 26.453 | 7.793 | 5.413 | ||
| Alkenes | ||||||
| AK1 | Myrcene | 14.365 | ND | 0.393 ± 0.01 | ND | ND |
| AK2 | Dipentene | 15.573 | ND | 0.33 ± 0.021 | ND | ND |
| AK3 | d-Limonene | 15.573 | 1.1 ± 0.075 b | ND | 3.999 ± 0.402 a | ND |
| AK4 | 1,5-Hexadiene | 25.458 | ND | ND | ND | 5.108 ± 0.25 |
| ∑ | 1.1 | 0.723 | 3.999 | 5.108 | ||
| Disulfide | ||||||
| DI1 | Dimethyl disulfide | 11.392 | ND | 0.4 ± 0.038 b | 0.182 ± 0.011 c | 0.515 ± 0.028 a |
| ∑ | 0 | 0.4 | 0.182 | 0.515 | ||
| Hydrocarbon | ||||||
| HY1 | Hydroxymethyl cyclopropane | 13.579 | ND | ND | ND | 0.171 ± 0.017 |
| HY2 | 1,2-Epoxy-2-methylbutane | 17.029 | ND | 0.44 ± 0.039 b | ND | 1.09 ± 0.194 a |
| HY3 | n-Tridecane | 18.165 | ND | ND | 0.991 ± 0.024 | ND |
| HY4 | 2-Aminobutane | 29.306 | ND | 0.37 ± 0.015 | ND | ND |
| HY5 | 2,3-Epoxybutane | 33.101 | ND | ND | 0.286 ± 0.01 | ND |
| ∑ | 0 | 0.81 | 1.277 | 1.261 | ||
| Azoles | ||||||
| AZ1 | 1h-1,2,4-Triazolo-3-thiols | 15.573 | ND | ND | ND | 0.404 ± 0.02 |
| AZ2 | 3-Mercapto-5-methyl-1,2,4-triazole | 17.029 | ND | ND | ND | 5.236 ± 0.21 |
| ∑ | 0 | 0 | 0 | 5.64 | ||
| Amides | ||||||
| AM1 | Propionamide | 27.566 | 0.46 ± 0.02 b | 1.17 ± 0.16 a | 0.109 ± 0.03 c | ND |
| AM2 | n,n-Dimethylformamide | 19.144 | ND | 0.6 ± 0.02 | ND | ND |
| ∑ | 0.46 | 1.77 | 0.109 | 0 | ||
| Aromatics | ||||||
| AR1 | Ethyl benzene | 13.579 | ND | ND | 0.126 ± 0.01 | ND |
| AR2 | 3-Dimethylbenzene | 13.579 | ND | ND | 0.067 ± 0.01 | ND |
| ∑ | 0 | 0 | 0.193 | 0 | ||
| Amino-compound | ||||||
| AC1 | Sec-butylamine | 10655 | 1.34 ± 0.13 | ND | ND | ND |
| AC2 | 1,2-Dimethylpropylamine | 11.392 | ND | 0.17 ± 0.02 | ND | ND |
| AC3 | N-methyl-1,3-propanediamine | 24.02 | 0.69 ± 0.011 | ND | ND | ND |
| AC4 | 2-Octylamine | 26.237 | ND | 0.66 ± 0.015 | ND | ND |
| ∑ | 2.03 | 0.83 | 0 | 0 | ||
| OT1 | Lactonitrile | 8.389 | ND | ND | ND | 2.242 ± 0.31 |
| OT2 | n-Butyl glycidyl ether | 12.032 | ND | ND | 0.019 ± 0.011 | ND |
| OT3 | n-Formylmorpholine | 17.029 | ND | 1.69 ± 0.022 | ND | ND |
| OT4 | Cyanoacetic acid | 25.458 | 0.88 ± 0.02 | ND | ND | ND |
| OT5 | 12-Crown ether-4 | 33.101 | 10.51 ± 0.46 a | 3.68 ± 0.64 b | 0.346 ± 0.006 d | 1.231 ± 0.018 c |
| OT6 | 15-Crown-5 | 33.101 | 6.19 ± 0.58 | ND | ND | ND |
| ∑ | 17.58 | 5.37 | 0.365 | 3.473 | ||
Disclaimer/Publisher’s Note: The statements, opinions and data contained in all publications are solely those of the individual author(s) and contributor(s) and not of MDPI and/or the editor(s). MDPI and/or the editor(s) disclaim responsibility for any injury to people or property resulting from any ideas, methods, instructions or products referred to in the content. |
© 2023 by the authors. Licensee MDPI, Basel, Switzerland. This article is an open access article distributed under the terms and conditions of the Creative Commons Attribution (CC BY) license (https://creativecommons.org/licenses/by/4.0/).
Share and Cite
Zhang, J.; He, Y.; Yin, L.; Hu, R.; Yang, J.; Zhou, J.; Cheng, T.; Liu, H.; Zhao, X. Isolation of Aroma-Producing Wickerhamomyces anomalus Yeast and Analysis of Its Typical Flavoring Metabolites. Foods 2023, 12, 2934. https://doi.org/10.3390/foods12152934
Zhang J, He Y, Yin L, Hu R, Yang J, Zhou J, Cheng T, Liu H, Zhao X. Isolation of Aroma-Producing Wickerhamomyces anomalus Yeast and Analysis of Its Typical Flavoring Metabolites. Foods. 2023; 12(15):2934. https://doi.org/10.3390/foods12152934
Chicago/Turabian StyleZhang, Jing, Yiguo He, Liguo Yin, Rong Hu, Jiao Yang, Jing Zhou, Tao Cheng, Hongyu Liu, and Xingxiu Zhao. 2023. "Isolation of Aroma-Producing Wickerhamomyces anomalus Yeast and Analysis of Its Typical Flavoring Metabolites" Foods 12, no. 15: 2934. https://doi.org/10.3390/foods12152934
APA StyleZhang, J., He, Y., Yin, L., Hu, R., Yang, J., Zhou, J., Cheng, T., Liu, H., & Zhao, X. (2023). Isolation of Aroma-Producing Wickerhamomyces anomalus Yeast and Analysis of Its Typical Flavoring Metabolites. Foods, 12(15), 2934. https://doi.org/10.3390/foods12152934

